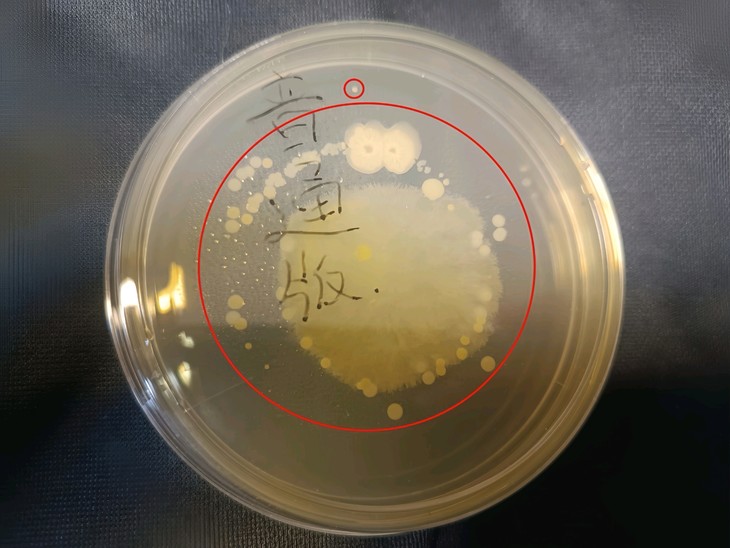
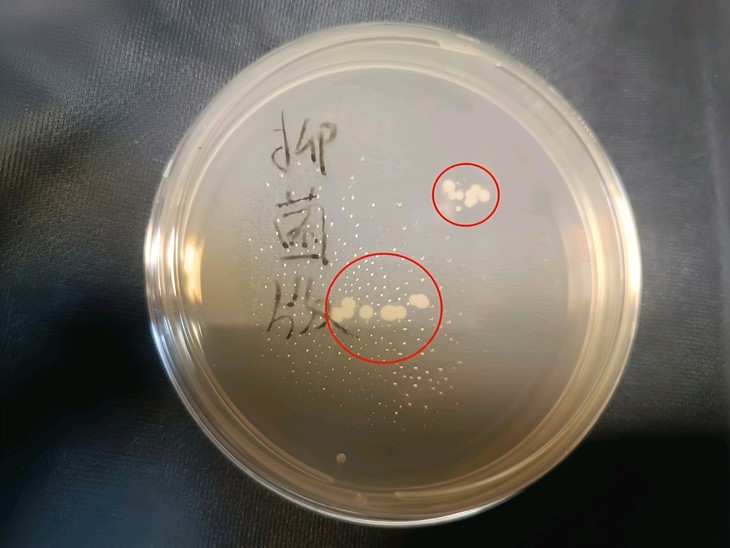

【怪兽女孩测评】
作者:萝莉的魔法
id:84244
精致女孩👧一定要知道的养护㊙️
白夜魔系列上架也有一段时间了!萝莉为了让老婆们更清晰地看到抑菌版的实力,专门安排了一场小实验(先说明下哦,内容仅供参考,咱求同存异,可不兴抬杠哈~)。考虑到要还原老婆们的日常使用情境,这次实验把抑菌版、原版普通版,还有用清洁湿巾仔细擦拭后的普通版,这三种情况摆到一起做了对比,能让老婆们对抑菌版的玩具能力看的更直观!

🧪实验材料准备
1. 产品样本:萝莉准备抑菌版、普通版(来自其他品牌),保证样本无明显外观瑕疵。
2. 实验耗材:无菌琼脂培养皿3个,皿盖密封良好、琼脂均匀平整无干裂;清洁喷雾(日常用于玩具清洁消毒、成分明确);餐巾纸若干,质地柔软、不掉屑、吸水性良好。
🧪实验环境搭建与前期处理
1. 在窗台通风区域作为实验操作及静置场地。
2. 将抑菌版、普通版玩具放置在选定窗台通风处静置24小时,模拟日常存放环境。24小时后,用流动清水缓慢冲洗15秒,模仿使用后清洗场景,确保玩具表面无明显污渍残留,随即用餐巾纸轻轻吸干表面水分,动作轻柔避免二次污染。
3. 针对普通版玩具,手持清洁喷雾,距离玩具表面约15-20厘米,均匀喷洒,使喷雾覆盖整个表面至微微湿润状态后,立即用餐巾纸沿同一方向擦拭,直至表面干爽无液体残留。
🧪实验操作流程
1. 将抑菌版、清洁后普通版、未清洁普通版玩具,依次将玩具表面紧密按压在琼脂培养皿中央区域,每个样本使用单独培养皿,避免交叉污染,按压时间保持 5 秒确保充分接触,轻微转动玩具使不同部位均能沾染培养基。
2. 标记好培养皿对应样本信息后,放置在温度为 30 摄氏度环境中培养时长 48 小时,培养期间避免震动、光照干扰。
🧪实验结果观测与分析
1. 48小时培养期满后,取出培养皿,避免晃动致使菌落脱落模糊结果。观察培养皿内的菌落形态、颜色、大小、数量进行细致统计,区分不同样本培养皿。
2. 对比数据清晰显示:普通版培养皿表面布满大量菌落,密集分布呈现片状或块状;抑菌版及清洁喷雾擦拭过的普通版培养皿表面仅零星分布少量菌落,多为孤立分散状态,数量寥寥可数,二者总菌落数接近,抑菌版与普通版菌落数存在极显著差异,而抑菌版和清洁处理后的普通版接近,确凿证实抑菌版具备超强抑菌能力,能有效抑制微生物在玩具表面滋生繁衍,为日常使用卫生安全提供有力保障。
❗️(图片中白色的小点就是培养后的细菌)❗️
所以老婆们,在我们使用玩具的前后一定要做好清洁工作,保护好我们的小花园!
为什么要用清洁喷雾❓
1、从卫生健康角度看,小玩具是直接接触我们的🌺的,🌺上的黏膜娇嫩、菌群平衡敏感,易受外界病菌侵袭。每次使用后,残留体液是细菌、真菌滋生的“温床”,如大肠杆菌、金黄色葡萄球菌、白色念珠菌等有害菌,可迅速繁殖引发瘙痒、异味、炎症,像霉菌性阴道炎、尿道炎等疾病悄然盯上我们。
2、材质养护层面,小玩具材质多样,硅胶、橡胶、TPE等各有特性,普通清洁剂酸碱不当容易腐蚀老化材质,致表面黏腻、变形、开裂,缩短使用寿命。专用清洁喷雾精准适配,pH值温和呈中性或弱酸性,契合材质耐受度,去污同时形成保护膜,维持柔软度与弹性,确保每次使用触感如初。
3、便捷高效方面,相较繁琐消毒流程,喷雾一喷一擦即净。忙碌生活节奏下,无需大费周章准备热水、消毒器具,几秒钟操作就能为下次愉悦体验备好洁净用品,契合现代人高效、私密需求,无论是差旅途中还是居家日常,随时保障私密健康与情趣时光品质。 总之,清洁喷雾是情趣用品使用闭环中关键一环,为私密愉悦筑牢安全防线。
如何正确的清洁小玩具❓
1. 及时初步清洁:使用完毕,趁体液残留未干时在流水下冲洗,水温30-40℃为宜,接近人体体温,避免材质骤热骤冷受损。像硅胶类玩具,轻柔搓洗表面,初步去除大部分分泌物,动作需轻缓,防止拉扯导致玩具表面的液态硅胶变形,尤其对有纹理、凸起设计的部位重点冲洗。
2. 深度清洁选对清洁剂:普通肥皂、洗洁精含强碱或香料,易腐蚀材质、刺激私密肌肤,专用清洁喷雾是不二之选。使用时,先摇匀喷雾,距玩具表面15-20厘米均匀喷洒,确保覆盖所有角落,硅胶玩具缝隙、孔洞较多,喷头精准对准,让清洁液渗透。喷雾成分针对常见病菌,如可高效灭活引发私处炎症的念珠菌、大肠杆菌等,杀菌率高达99%,且无有害残留。
3. 细致擦拭与冲洗:喷完稍等3-5分钟,待清洁成分充分作用,用柔软无纺布或专用清洁布轻拭,按纹理走向单向擦拭,带走污垢与病菌。之后再用温水彻底冲洗,水流速适中,检查无滑腻感、异味才算清洁干净。
4. 擦干水分是关键,可自然晾干,置于通风无尘处;或用干净毛巾吸干,不要大力的扭转。完全干燥后,收入防尘袋或密封盒,存于阴凉避光抽屉,避免阳光直射加速老化,硅胶制品远离含氯、酒精高的日化品,防止化学反应。
老婆们,萝莉希望通过这场实验能让大家都能把健康牢牢握在手中。要是预算充足,别犹豫,直接入手抑菌版准没错!预算稍紧的选普通版也完全没问题,但请务必加购清洁喷雾哦!几毫升的喷雾蕴含着大大的能量,能补齐普通版在抑菌上的短板,让小玩具始终洁净如新,守护好自己的那片“小花园”。
生活再忙碌,别在关乎自己健康的事儿上打折扣。愿每位小宝在快乐后都能守护你的私处健康,每一次玩耍后都能愉悦洁净,养成良好的习惯,才能好好守护我们的“秘密花园🌺”!尽情拥抱美好的生活!